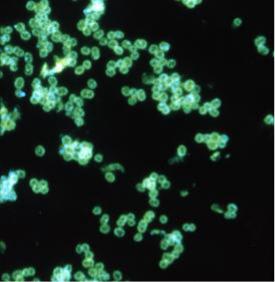

Материал: Нейссерии
31
Для дифференцировки гонококков от других грамотрицательных бактерий применяют прямой и непрямой варианты РИФ (рисунок 43).
Рисунок 43 - Иммунофлюоресценция гонококков.
При прямом варианте мазки обрабатывают флюоресцирующими антителами против гонококков, при непрямом методе используют гонококки, сыворотку больного и антиглобулиновую сыворотку.
Бактериологическое исследование проводят при отсутствии гонококков в мазках или при обнаружении атипичных форм. Этот метод позволяет выявлять гонококки в 1,5-4 раза чаще, чем микроскопическое исследование. Особенно показаны посевы при хронической гонорее, гонорейном проктите и контроле на излечение. Посев материала производят непосредственно после отбора на сывороточный или асцитический агар. Добавление к среде ристомицина и полимиксина М (10 ЕД/мл) значительно повышает высеваемость гонококков. Посевы инкубируют в атмосфере углекислого газа (10%).
Серологический метод используют при хронической гонорее, а также в случае отсутствия у больного выделений. В качестве серологического метода используют РСК (реакцию Борде-Жангу). Реакция становится положительной с 3-4 недели заболевания. При острой форме болезни она положительна у 35% больных, при хронической форме - у 65% (слабоположительная у 100%). В качестве антигена для РСК применяют гоновакцину или антиген из убитых гонококков.
В настоящее время для диагностики гонореи рекомендована полимеразная цепная реакция (ПЦР). Для забора материала используются эндоцервикальные, влагалищные тампоны и мужские уретральные тампоны. Методом ПЦР можно исследовать и мочу. Этот метод не рекомендован для исследования материала из ротоглотки и прямой кишки в связи с возможностью перекрестных реакций с другими нейссериями.
Лечение гонококковой инфекции зависит от формы заболевания. При острой и подострой гонорее применяют антибиотики группы пенициллина. При непереносимости пенициллина используются другие антибиотики. Через 5-7 дней антибиотикотерапии воспалительные явления уменьшаются, выделения становятся

32
скудными, гонококки в них не обнаруживаются. По истечении 7-10 дней определяют излеченность заболевания.
При хронической гонорее применяют специфическую (гоновакцина) или неспецифическую (пирогенал) иммунотерапию и местное воздействие на пораженный орган. После такого воздействия в стационарных условиях проводят курс антибиотикотерапии повышенными дозами антибиотиков.
Для контроля излеченности прибегают к провокации химическим, механическим, алиментарным или термическим методом. После провокации через 24, 48 и 72 часа исследуют выделения. При отсутствии после провокации гонококков в мазках и посевах больного оставляют для диспансерного наблюдения. Через месяц повторяют провокацию и делают уретроскопию. Если в течение этого срока возбудитель и клинические проявления болезни отсутствуют, то таких лиц снимают с диспансерного учета.
В настоящее время в России в соответствии со стандартом медицинской помощи больным гонококковой инфекцией методы провокации не используются. Поэтому контроль излеченности проводят через 2 и 14 дней после окончания лечения.
Профилактика гонококковой инфекции включает следующие мероприятия:
-активное выявление и лечение больных и их половых партнеров с последующим контролем на излеченность;
-обязательное обследование декретированных групп населения (работники детских дошкольных учреждений и общепита) перед поступлением на работу и в последующем через каждые три месяца;
-обязательная первичная обработка новорожденного (закапывание в конъюнктивальную полость обоих глаз по одной капле 2% раствора азотнокислого серебра или сульфацила натрия) для профилактики бленнореи (рисунок 44).
Рисунок 44 - Профилактика офтальмии новорожденных.
Основное внимание в профилактике гонококковой инфекции принадлежит санитарно-просветительной работе, направленной на пропаганду здорового образа жизни и исключение случайных половых связей.
33
Вопросы для контроля усвоения материала
1.Расскажите о морфологических, культуральных и биохимических особенностях нейссерий.
2.Охарактеризуйте антигенную структуру менингококков.
3.Что относится к факторам патогенности менингококков?
4.Расскажите о патогенезе менингококковой инфекции.
5.Как клинически проявляется менингококковая инфекция?
6.Каковы особенности лабораторной диагностики менингококковой
инфекции?
7.Расскажите о профилактике и лечении менингококковой инфекции.
8.Какова антигенная структура гонококков?
9.Что относится к факторам патогенности гонококков?
10.Расскажите о патогенезе гонококковой инфекции.
11.Как клинически проявляется гонококковая инфекция?
12.Что такое офтальмия новорожденных и каковы ее причины?
13.Расскажите о лабораторной диагностике гонококковой инфекции.
14.Расскажите о профилактике и лечении гонококковой инфекции.
Тренировочные тесты
1.Нейссерии представляют собой: - грамположительные палочки - грамотрицательные палочки
+ грамотрицательные диплококки - спорообразующие палочки - стафилококки
2.К патогенным для человека нейссериям относятся:
+ Neisseria meningitidis + Neisseria gonorrhoeae - N. flava
- N. subflava - N. mucosa
3.Для менингококков характерно:
+грамотрицательные бактерии
+диплококки
-стрептококки
-стафилококки
+ спор не образует
4. Возбудителем менингококковой инфекции является:
-вирус
-тетракокк
34
-стрептококк + диплококк
-стафилококк
5. Менингококки отличаются от гонококков по следующим свойствам: - морфологии
+биохимическим свойствам - спорообразованию
+патогенезу вызываемых заболеваний
+антигенным свойствам
6. К факторам патогенности менингококков относятся: - жгутики
+гиалуронидаза
+IgА-протеаза
+эндотоксин
- экзотоксин
7. Источником инфекции при менингококковом менингите являются:
-инфицированные продукты
-предметы обихода
+ больные, бактерионосители
-медицинский инструментарий
-вода
8. Наиболее типичным признаком менингококцемии является: - полиартрит + геморрагическая звездчатая сыпь
-бледность кожных покровов
-менингеальные симптомы
-эндокардит
9.Выделение менингококка из носоглотки при отсутствии клинических признаков наблюдается при:
- генерализованной менингококковой инфекции + бактерионосительстве - менингококковом менингите
- менингококковом назофарингите - менингококцемии
10.Жалобы больных менингококковым назофарингитом:
+повышение температуры
+головная боль
+сухой кашель
+насморк
+першение в горле
35
11. Наиболее эффективный метод лабораторной диагностики менингококкового менингита:
-бактериологическое исследование носоглоточной слизи
-бактериологическое исследование крови
+ бактериологическое и бактериоскопическое исследование ликвора
-биопроба
-серологические реакции
12. Укажите абсолютные показания для люмбальной пункции:
-сильная головная боль
-рвота
-головная боль, высокая температура
-высокая температура, рвота
+ положительный менингеальный синдром
13. Микробиологическая диагностика менингококковой инфекции включает:
+микроскопический метод
+бактериологическое исследование
+серологические реакции
-аллергические пробы
-биопробу на крысах
14. Основным методом микробиологической диагностики менингококкового назофарингита является:
-бактериоскопический + бактериологический
-серологический
-аллергический
-биологический
15. Экспресс-диагностика менингококкового менингита предусматривает определение:
- серовара возбудителя + антигена возбудителя в СМЖ
-общего титра антител в крови
-нарастания титра антител в сыворотке
-класса иммуноглобулинов
16. Менингококковая бивакцина является:
-генно-инженерной
-корпускулярной + химической
-живой
-анатоксином